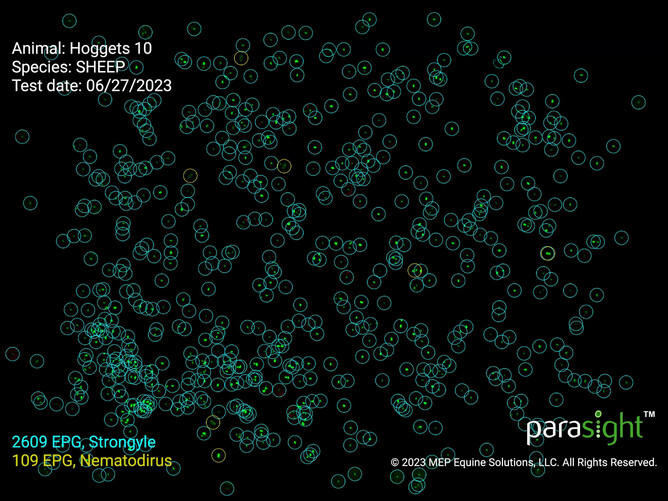
This is a result from our Parasight FEC machine, which is a highly sensitive and specific testing technique. This sample was taken from hoggets.

Test before you drench to get the most out of your products, time and, most importantly, stock!
Youngstock performance has a massive impact on your bottom line and effective parasite management has a massive impact on youngstock performance!
Drenching is part of effectively managing parasites and we need to ensure that every drench counts.
In the past, Southern farmers have listened to warnings of drench resistance from our farming counterparts in the North. But, now we are seeing a lot of drench resistance on our patch too.
We are also hearing about poor stock performance and lamb growth in the region and, in some cases, we find drench resistance to be an issue.
Checking the efficacy of drench
There are a number of ways to test your drench to find out if it is effective or not. Currently, all testing is done using Faecal Egg Counts (FEC), which show how many eggs are coming out, and Larval Cultures (LC), which show what worm species are present.
Our new Parasight FEC machines allow us to process your FEC tests in-clinic and we aim to get your results back on the same day (when samples are delivered to the clinic before 3pm).
FECRT
A full Faecal Egg Count Reduction Test (FECRT) is the most comprehensive way to test the efficacy of your drench. It compares the change in the faecal egg count before and after drenching to give you a more accurate indication of whether your drench is working.
Visits are required about 14 days apart and faecal samples taken at each visit will have FEC and LC tests done on them, which take about 2 weeks to get back from the lab.
You can test several mobs with different drenches to see which (if any) active ingredients they have resistance to. In the past, clients have tested single active drenches alongside dual, triple and/or novel drenches. However, singles are not sold anymore and are unavailable to test.
We see testing the drenches you are currently using (or may use) as a useful compromise. This will reduce the number of test groups, animals used and cost compared to previous FECRTs you may have done.
We expect to see many farms testing 2-3 actives this year, which would call for 30-45 animals.
The drenches we have available to test are:
Clear/White - Corporal, Scanda
Clear/Abamectin - Boss Dual, Converge
Clear/White/Abamectin - Matrix, Boss, Triple A
Moxidectin
Abamectin/Monepantel - Zolvix
Abamectin/Derquantal - Startect
We would recommend that FECRT tests are repeated on farms every 2-3 years.
Drench Check
Alternative to, and in conjunction with, a FECRT, we can run some Drench Checks on your farm. This is when you bring us 10 individual samples for testing, 10-14 days after you have drenched your stock.
If we see eggs coming through, we may suggest adding an LC to help analyse what is going on.
Your KeyVet will be able to discuss with you which option is the most appropriate for this year and set up something that suits your farming system.
You spend so much time and money drenching lambs, you need to know it's worthwhile!